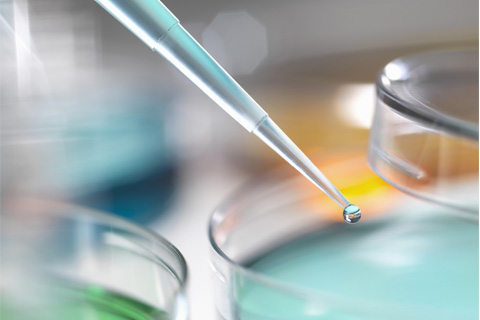

主要翻译服务

文件翻译
译心国际武汉翻译公司为您提供各种证件翻译、项目文件翻译、商务公文翻译、法律合同文书翻译、各种商业投资翻译等。

口译服务
个人或商务出国陪同翻译,外事接待、工程安装、劳动派遣翻译,线上会议口译,电话口译,会议速记录入等。

听译、配音
国内外影视作品、视频短片等翻译配音、刻字幕,提供外语、方言等视频、录音听译转写文字等专业服务。

同传、交传
通过ISO-9001国际质量管理体系认证的同声传译服务,交替传译,国内外专家同传译员,专业翻译品牌保障!
翻译语种

泰语翻译
价格:320元-450元/千字

越南语翻译
价格:320元-450元/千字

印尼语翻译
价格:320元-450元/千字

葡萄牙语翻译
价格:320-420元/千字

韩语翻译
价格:150元-220元/千字

日语翻译
价格:150元-220元/千字

英语翻译
价格:120元-200元/千字

俄语翻译
价格:250-320元/千字

法语翻译
价格:240元-320元/千字

德语翻译
价格:240元-320元/千字

西班牙语翻译
价格:270元-350元/千字

意大利语翻译
价格:280元-360元/千字
每一次高质量交付,为了成功殚精竭虑。携手同行,共同成长。
100%规范的翻译流程
100%以严格的流程来保证交付质量
100%严格保密承诺
100%文件资料保密,100%信守承诺
100%快速准时的能力
100%按时交付,守时是译心翻译必备的素质
100%无忧终身服务
100%无忧服务,译前可试译,译后终身质保
行业翻译解决方案
医疗行业翻译
生物技术翻译、医疗器械说明书、药品说明书、医学论文、生物医药、药品专利等

电力行业翻译
电力招投标文件翻译、电力设备产品施工说明、电力技术文档及设计图纸资料等。

建筑工程翻译
建筑工程图纸、相关技术文件、相关商务文件及建筑工程招投标文件翻译。

交通行业翻译
交通行业各种产品应用说明、方案说明文件、交通工程招投标文件翻译。

机械行业翻译
机械行业招投标文件、产品说明书、技术文档、图纸资料等。

金融行业翻译
保险 、证券期货、税务翻译、 审计翻译、 财务报告翻译、金融论文翻译等

通信行业翻译
通信行业方案、技术手册、图纸、招投标文件等的翻译。

化工行业翻译
有机化工、石油化工、生物化学、化工填料、日用化工、高分子化工等。
专职人才
127
翻译人才
5000
合作客户
69888
客户遍布全球国家
55























